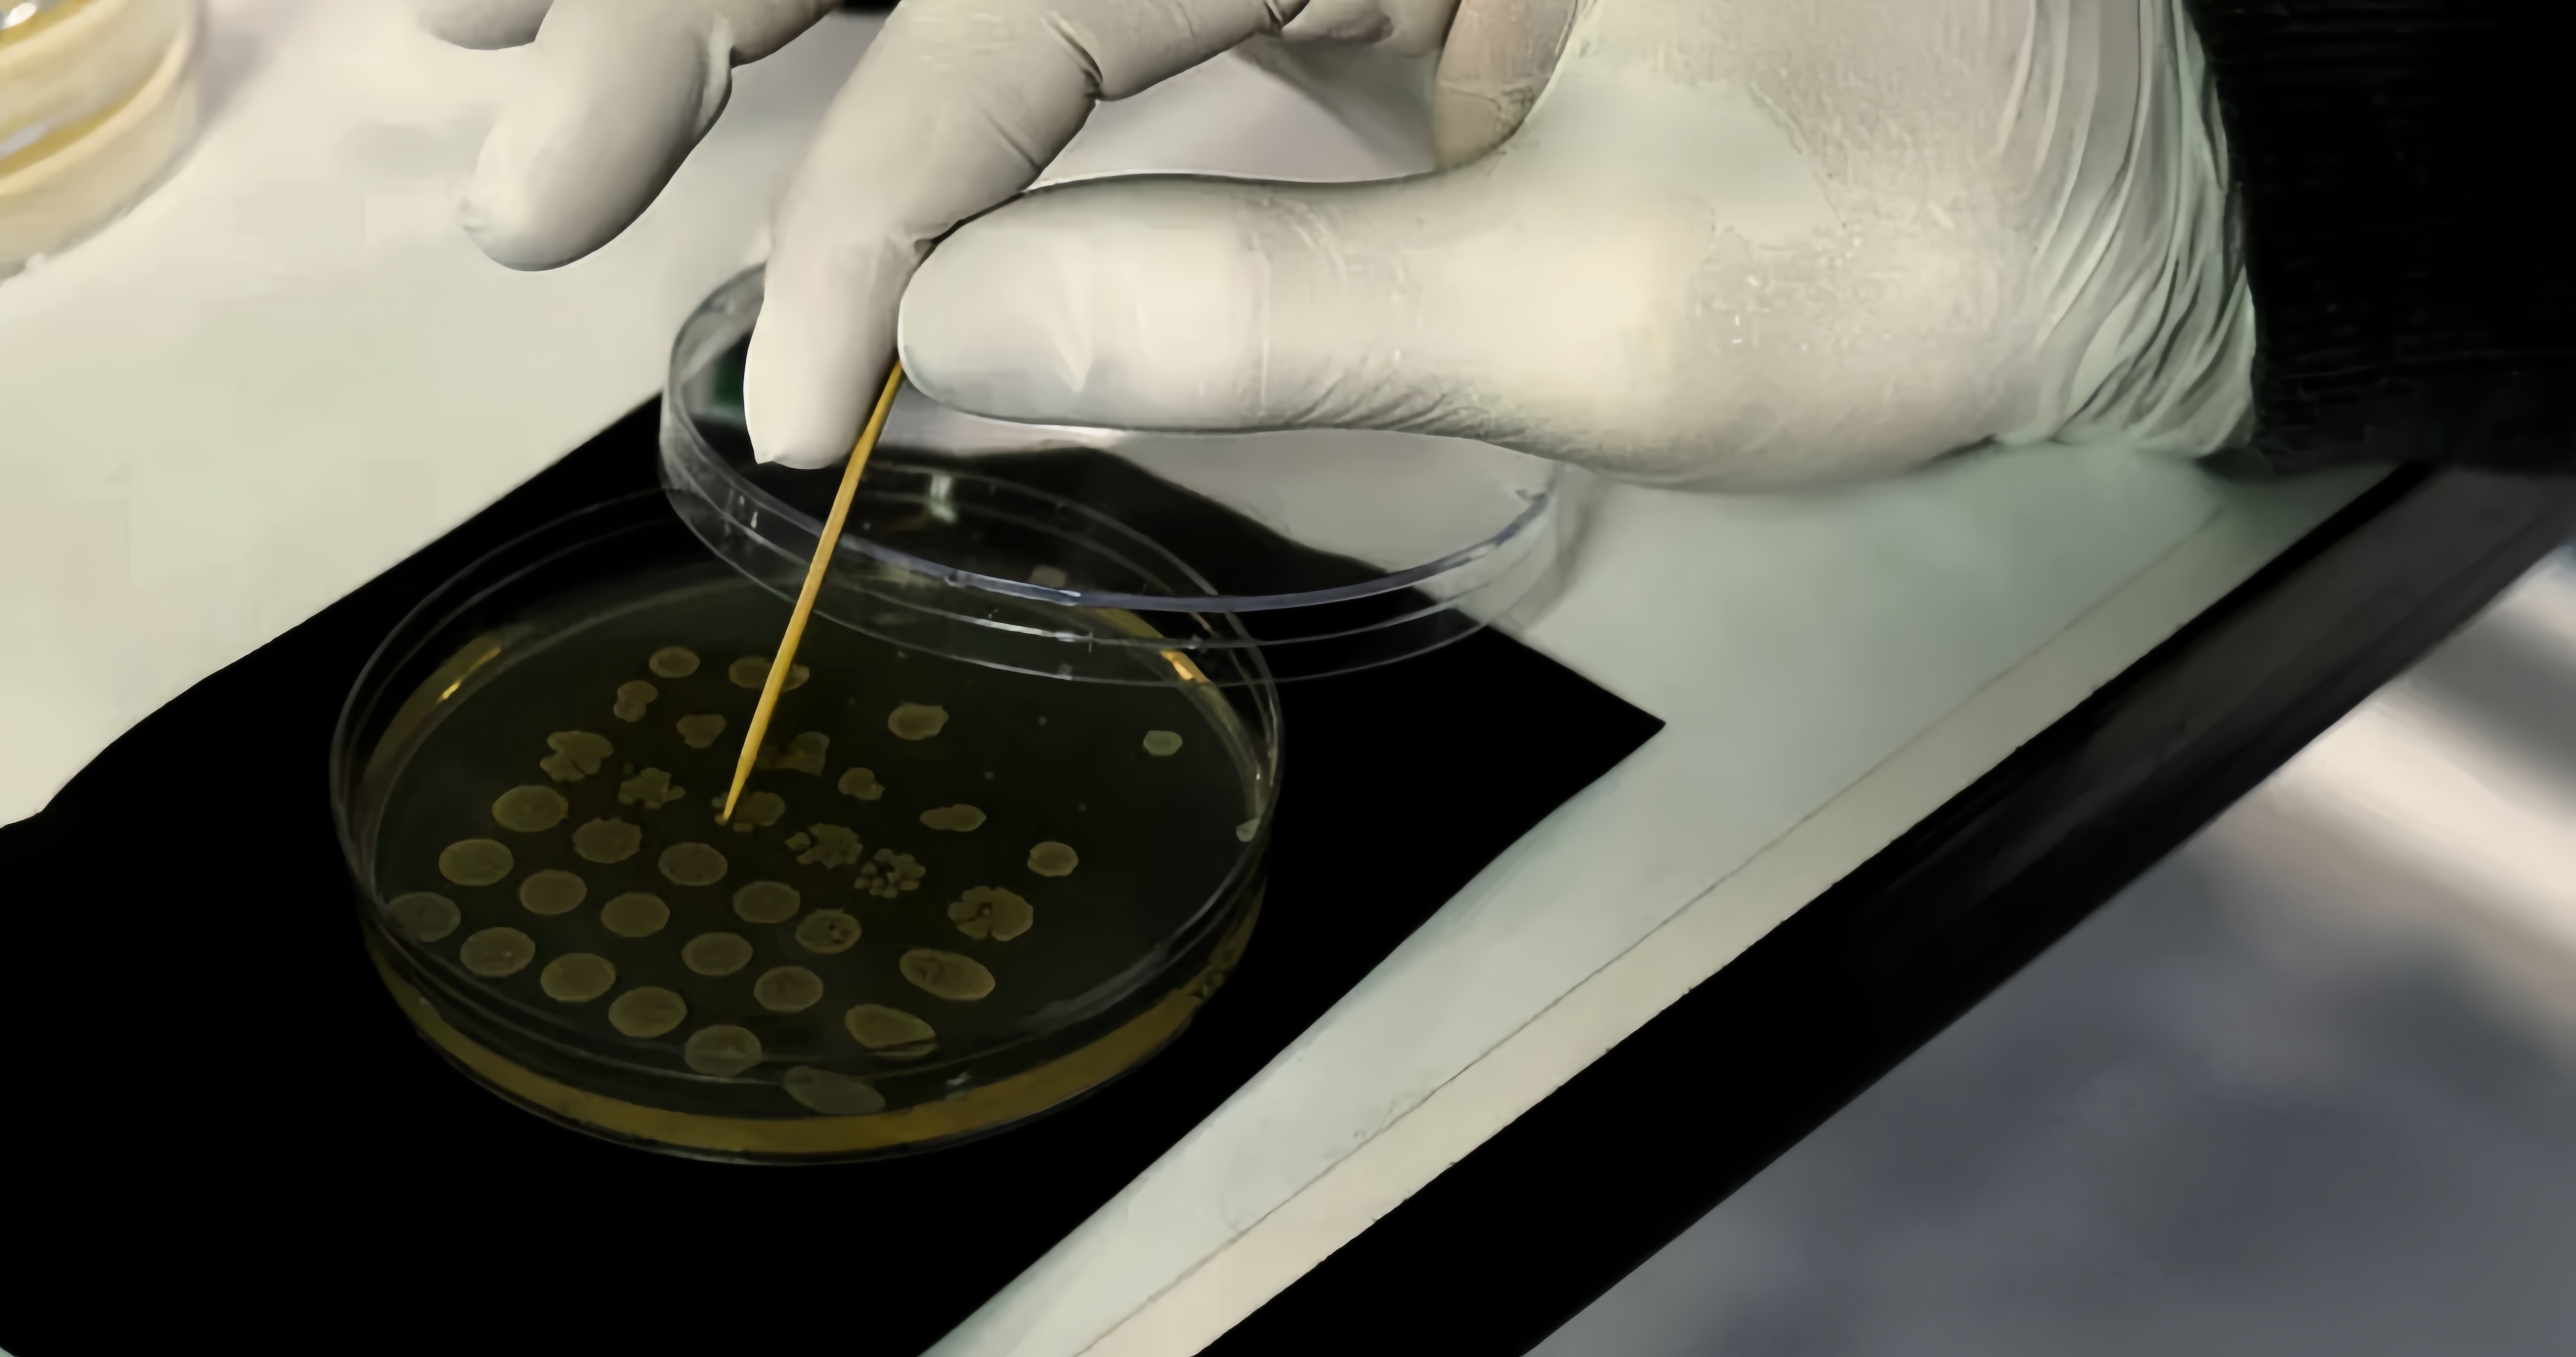
Pre-Alcohol

ZBiotics
ZBiotics — Feel Better After Drinking, Wake Up Refreshed, Science-Backed, Patented Probiotic for Easier Mornings, Travel-Friendly, 6-Pack of 0.5 Fl Oz Bottles
Share this product

ZBiotics: The World's First Drinking Probiotic

Drink a Pre-Alcohol
For best results, make Pre-Alcohol your first drink of the night.

Drink responsibly
Whether it’s a glass of wine with dinner or going out with friends, pace yourself, hydrate, and get a good night’s sleep.

Enjoy tomorrow
Seize your next day—hit the gym, get outside, play with the kids—make the most of it.

World's first genetically engineered probiotic
- Trusted by customers
GRAS & FDA safety compliant
Responsibly engineered
Transparently labeled
How to use

1 Drink Pre-Alcohol
Make it your first drink of the night.

2 Drink responsibly
Pace yourself, hydrate, and get a good night's sleep.

3 Enjoy tomorrow
Wake up refreshed.
It's not magic,It's science

Alcohol produces acetaldehyde
That byproduct is largely responsible for how we feel the day after drinking.

Acetaldehyde builds up in the gut
The liver produces an enzyme that removes it quickly. But the gut does not. So acetaldehyde builds up and lingers, filtering out into the rest of our body over time.

Pre-Alcohol breaks it down
This probiotic – Bacillus subtilis ZB183™ – has been engineered to produce the same type of enzyme as our liver: one that digests acetaldehyde.

Proudly built with genetic engineering
Our approach to biotechnology is safety-first and grounded in the strictest ethical principles. We build responsibly or we don’t build at all. Pre-Alcohol undergoes rigorous quality testing at every stage, and we transparently publish our findings on our Quality page
Pre-Alcohol

The Problem
Here’s the problem. The body has many biological reactions to drinking alcohol, not all of which are pleasant. The metabolism of alcohol produces a variety of small molecules and cellular responses which, when piled-up, can be hard on your body and throw you off your healthy routine. One of those small molecules is acetaldehyde, an unwanted, toxic byproduct of alcohol metabolism. Its chemical structure is highly reactive, which means it can interact with a whole host of molecular and cellular components throughout our bodies. But how does alcohol become acetaldehyde?

When you drink, most of the alcohol you consume gets digested in the liver using a two-step process (see diagram). Each step requires a different enzyme produce by your liver.
1. Alcohol dehydrogenase (ADH) converts ethanol into acetaldehyde by removing hydrogen atoms—a process called oxidation.
2. Acetaldehyde dehydrogenase (ALDH) then further oxidizes acetaldehyde into acetate by adding an oxygen atom, producing a more stable and innocuous compound.
However, some of the alcohol you drink never reaches your liver. Instead, it is metabolized in your gut, in large part by the microbes that reside there. Some microbes in the gut microbiome are equipped with the first enzyme, ADH, and can convert alcohol into acetaldehyde. But in contrast to your liver, they don’t make enough of the second enzyme, ALDH, to convert acetaldehyde into acetate. This is the major cause of acetaldehyde buildup in your body
Thus arises a clear hypothesis: If we can equip the gut microbiome to break down acetaldehyde into acetate, we can support the body’s ability to minimize the buildup of this toxic byproduct. While the liver is fully capable of metabolizing acetaldehyde, the gut is not—and that gap makes this approach especially valuable for those planning to have a drink or two.
The Solution
If you’re trying to enable the gut microbiome to break down acetaldehyde, the most straightforward approach would be to make a bunch of the same enzyme your liver uses (ALDH) and deliver it to the gut, mimicking exactly what your body already does so effectively. Unfortunately, in this case (and most cases really) we can’t just eat an enzyme to equip our bodies with new traits. Enzymes are proteins, and most proteins you consume will break down very quickly as food in your stomach. Once broken down they lose their function.
But our scientists knew three very interesting things:
1.There are probiotic bacteria that can survive the harsh environment of the stomach unharmed.
2.Many bacteria are capable of making ALDH – the very enzyme our livers use to break down acetaldehyde.
3. We can use genetic engineering to create a probiotic bacteria with the ability to make ALDH!
So rather than trying to solve the problem with an enzyme that won’t survive in the gut, we can instead use genetic engineering to build a probiotic bacteria that not only makes the enzyme but can also deliver it safely to where it's most needed to break down acetaldehyde!
Though the actual building and testing behind our engineered ZB183™ strain took years, here is what we did on a basic level: We started with a natural probiotic bacteria called Bacillus subtilis. Humans have been intentionally consuming B. subtilis as a probiotic in supplements and fermented foods (e.g. natto, kombucha, etc.) for centuries. B. subtilis also has the natural ability to pass through your stomach acid unharmed and make enzymes in your gut (citation). We then used a process naturally honed by bacteria to insert the instructions for making ALDH into the bacteria’s genome, carefully selecting a location that optimizes the expression of this enzyme. The result was ZB183™ – a probiotic strain of B. subtilis that is identical in every way to the one humans already consume, but with one additional trait: the ability to break down acetaldehyde.
Data & Validation
Safety
We subjected ZB183™ to years of laboratory testing and review by America’s top food toxicologists, the results of which confirmed it to be completely safe and FDA-compliant. The data from these tests has been
Now that we have confirmed our genetically engineered probiotic is safe and works as intended, we make sure this is true of every batch. Pre-Alcohol undergoes rigorous quality testing at every stage, from probiotic biomass to the final product, ensuring safety, purity, and efficacy. We transparently publish our standards for each test on our Quality page

To confirm that ZB183™ worked as intended, we tested its ability to make ALDH and break down acetaldehyde. Over a series of laboratory tests where we compared it to the unedited B. subtilis strain, we confirmed that our Pre-Alcohol Probiotic was highly effective at producing ALDH. We also confirmed that while the control strain broke down almost no acetaldehyde, ZB183™ was able to break down more acetaldehyde than you could ever encounter when drinking. We published a paper containing the data from these tests, and it can be
As scientists we appreciate that every body is different and so there are no silver bullets in biology. Even though we’ve proven that the product can reliably provide the function of helping to metabolize acetaldehyde, we don’t know for sure that it will be perceived as valuable for everyone. However, we do know from customer use data that it does appear to provide a benefit to the vast majority of users (i.e. >95%). And with millions of bottles sold, that’s a lot of happy customers!
ZB183™ was our first proof of concept on a bigger journey to unlock the immense potential of safely and consciously-built genetically engineered microbes.

Founded by Scientists
Our founder, CEO, and inventor of the primary technology underlying Pre-Alcohol is Dr. Zack Abbott. Zack’s background is as a microbiologist; he received his PhD in Microbiology & Immunology from the University of Michigan. After that, he worked designing clinical trials for biotechnology and pharmaceutical companies prior to starting ZBiotics to bring the idea of genetically engineered probiotics to the world.
Our Mission

Unique products, built with genetic engineering

Transparency in our DNA

Setting the standard for GMO Safety

Elevating the conversation
This conversation needs to change. People need a new model for what GMOs can be. We are building just that, by creating GMO products with genetic engineering that is ethical, transparent, and beneficial to you—the end-user.

Collaborating for ethical engineering
What Our Customers Say
Read reviews from our satisfied customers.
"Survived Mardi Gras and never knew I had a drink. Cannot recommend any more highly!"
"I tried going through Ruthless but it didn't work. . . . because I would have never known without the podcast. . ."
"Something that I had never tried before but the outcome was very positive."
"My friend and I used it on a 7 day cruise. It worked great."
You probably have some questions
Check out our FAQs to find answers to common questions and feel free to reach out if you have more.
Your liver does not have access to your gut. But by drinking Pre-Alcohol, the goal is to augment your gut’s natural ability to digest acetaldehyde while you drink and while you sleep – helping you make the most of the next day. Just remember that Pre-Alcohol does not affect intoxication or make alcohol safer to drink, so always drink responsibly.
The probiotic in Pre-Alcohol needs time to “wake up” in your gut, so we say the earlier the better if you can remember it. We drink Pre-Alcohol just before going out – right before our first drink. But it should be active if you drink it any time during the day or evening. So whether it’s a few hours before drinking, right with your first drink, or even if you’ve already enjoyed a round or two, go for it.
Store Pre-Alcohol at room temperature with the cap on. Do not refrigerate. Do not open it until you’re ready to drink it; opening it could potentially let contaminants from the air into the bottle.
Note that FDA compliance is not FDA approval. FDA approval is a process reserved for drug products. Pre-Alcohol is a food/beverage product and has not been approved as efficacious for any purpose by the FDA.
Pre-Alcohol will not affect your level of intoxication. Pre-Alcohol does not decrease your blood alcohol level, nor does it make alcohol any safer.
We intentionally designed Pre-Alcohol so that it would not change your microbiome. We purposefully built our probiotic using a base bacteria that is well-adapted to passing straight through you and not colonizing your gut.
This creates a few likely benefits: (1) your microbiome remains unchanged; (2) the interaction between our probiotic and your gut should remain consistent and predictable; and (3) because we’re not trying to change your microbiome, we don’t need to use an excessive amount of probiotic per serving.